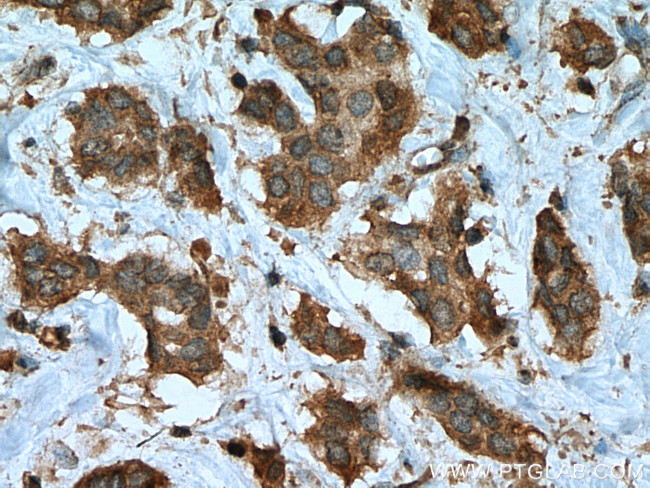
PTPN2 Antibody in Immunohistochemistry (Paraffin) (IHC (P))
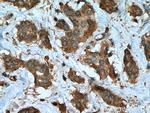
PTPN2 Antibody in Immunohistochemistry (Paraffin) (IHC (P))

Search
Proteintech
PTPN2 Monoclonal Antibody (2A1D1)
{{$productOrderCtrl.translations['antibody.pdp.commerceCard.promotion.promotions']}}
{{$productOrderCtrl.translations['antibody.pdp.commerceCard.promotion.viewpromo']}}
{{$productOrderCtrl.translations['antibody.pdp.commerceCard.promotion.promocode']}}: {{promo.promoCode}} {{promo.promoTitle}} {{promo.promoDescription}}. {{$productOrderCtrl.translations['antibody.pdp.commerceCard.promotion.learnmore']}}
产品信息
67388-1-IG
种属反应
宿主/亚型
分类
类型
克隆号
抗原
偶联物
形式
浓度
规格
纯化类型
保存液
内含物
保存条件
运输条件
产品详细信息
Aliquoting is unnecessary for -20°C storage.
靶标信息
T-cell protein tyrosine phosphatase (TC-PTP), also known as PTPT and PTPN2, is an enzyme that removes phosphate groups covalently attached to tyrosine residues in proteins. This enzyme has two C-terminal end splice variants with distinctly different subcellular localizations. The shorter 45 kilodalton isoform is exclusively nuclear in resting cells, but redistrubutes to the cytosol upon stimulation with growth factors and cellular stress. The longer 48 kilodalton isoform is exclusively found in the endoplasmic reticulum 3 and seems to have distinctly different physiologic substrates from the smaller isoform. Although found in many cell types and tissues, TC-PTP is particularly prominent in hemopoietic cell types. Knockout mice lacking TC-PTP are born viable but die 3 to 5 weeks after birth of erythropoietic and lymphopoietic deficits 7, indicating a critical role for TC-PTP in bone marrow maturation. TC-PTP will dephosphorylate a wide range of phosphoproteins, such as p52 Shc 6 and receptors for EGF 1, Insulin 8 and growth hormone.
仅用于科研。不用于诊断过程。未经明确授权不得转售。
篇参考文献 (0)
生物信息学
蛋白别名: MPTP; Protein-tyrosine phosphatase PTP-2; Protein-tyrosine phosphatase PTP-S; PTPN 2; T cell protein-tyrosine phosphatase; T-cell protein tyrosine phosphatase; T-cell protein-tyrosine phosphatase; TC PTP; TCPTP; tyrosine-phosphatase; Tyrosine-protein phosphatase non-receptor type 2; unnamed protein product
基因别名: AI325124; PTN2; PTPN2; PTPT; TC-PTP; TC45; TC48; TCELLPTP; TCPTP
UniProt ID: (Human) P17706, (Mouse) Q06180, (Rat) P35233
Entrez Gene ID: (Human) 5771, (Mouse) 19255, (Rat) 117063